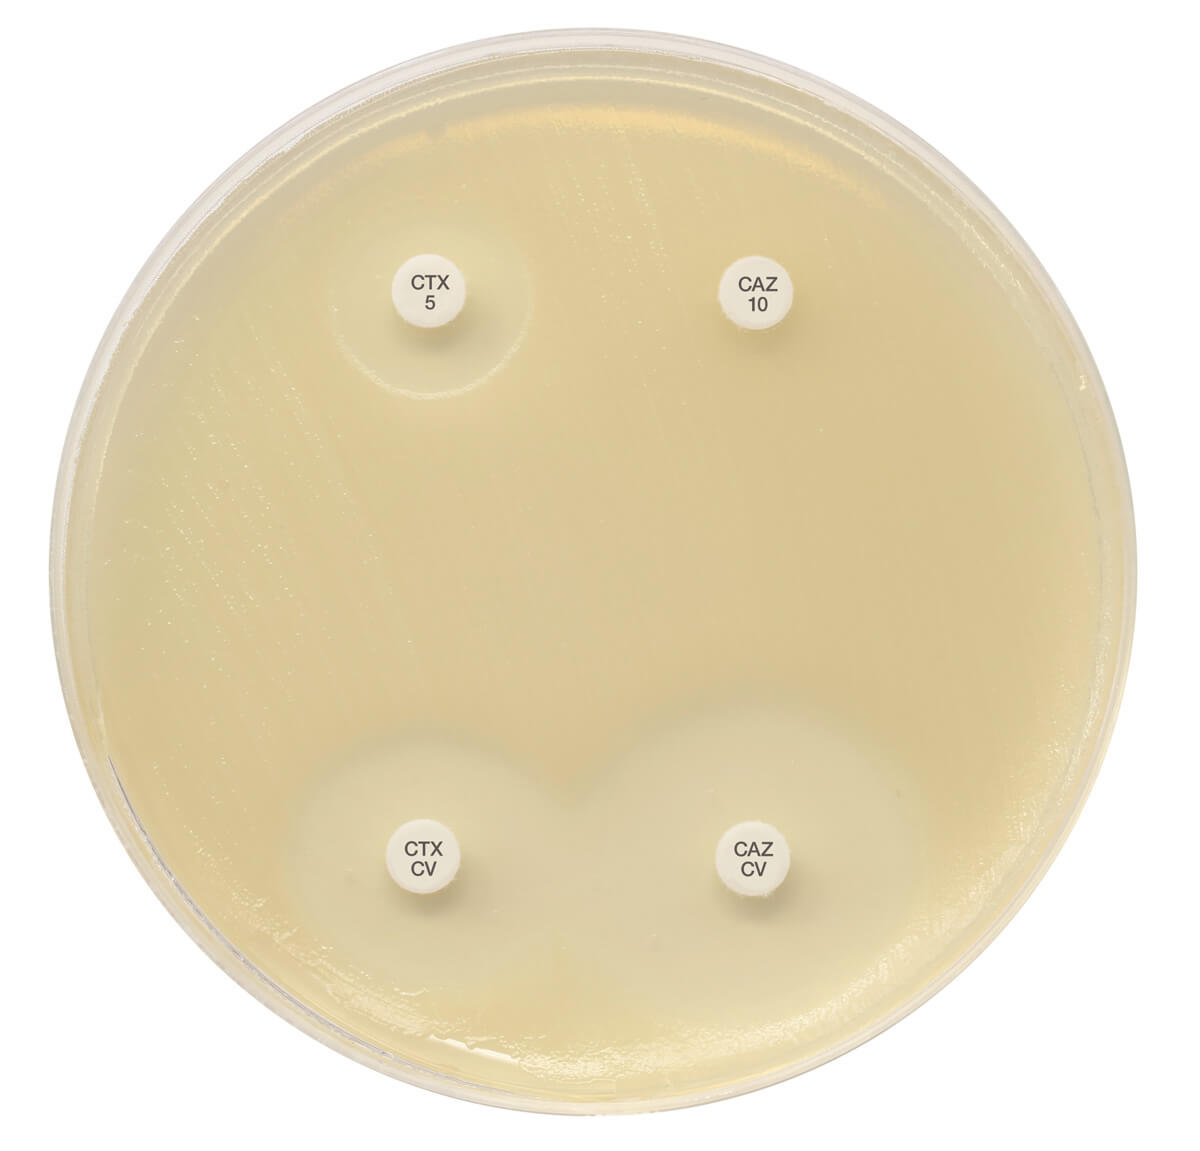
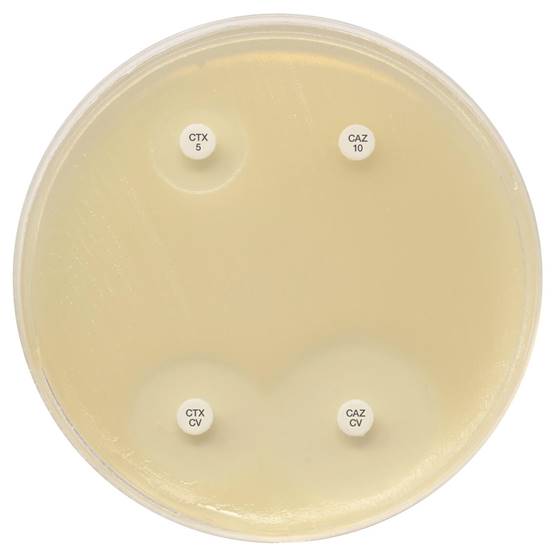
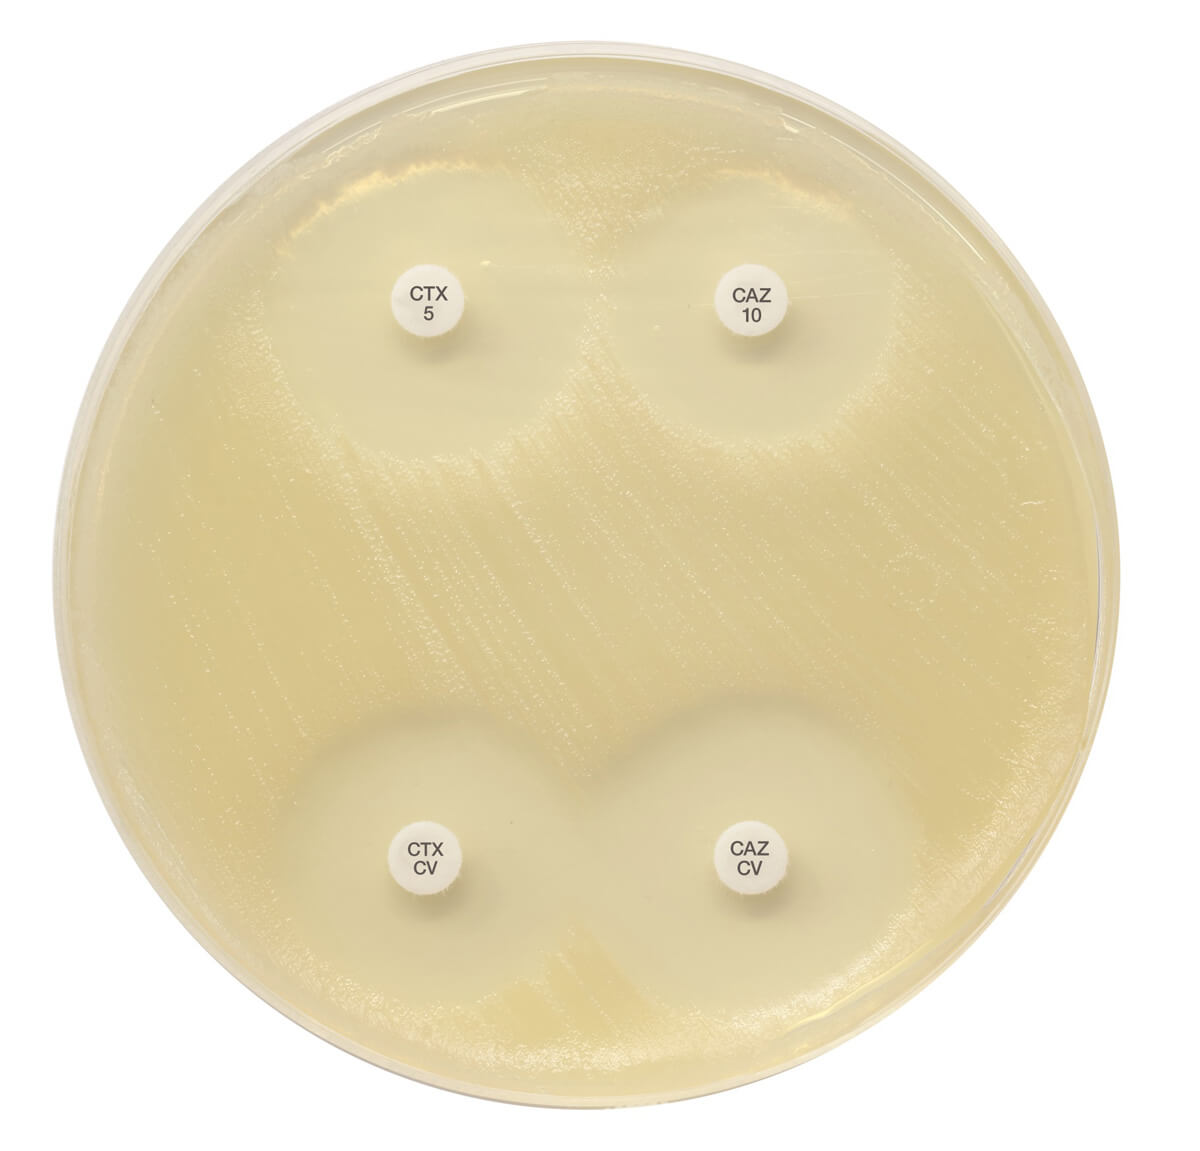

About the product
For the detection of Extended Spectrum Beta-Lactamases in Enterobacterales, using the new EUCAST recommended potencies:
1 x Cefotaxime 5µg discs
1 x Cefotaxime 5µg + Clavulanic acid 10µg discs
1 x Ceftazidime 10µg discs
1 x Ceftazidime 10µg + Clavulanic acid 10µg discs
NB: Please create an account or log in to download the calculator associated with this product from the 'General' tab above.
Related Products
MAST® DISCMASTER 6 PLACE DISPENSER